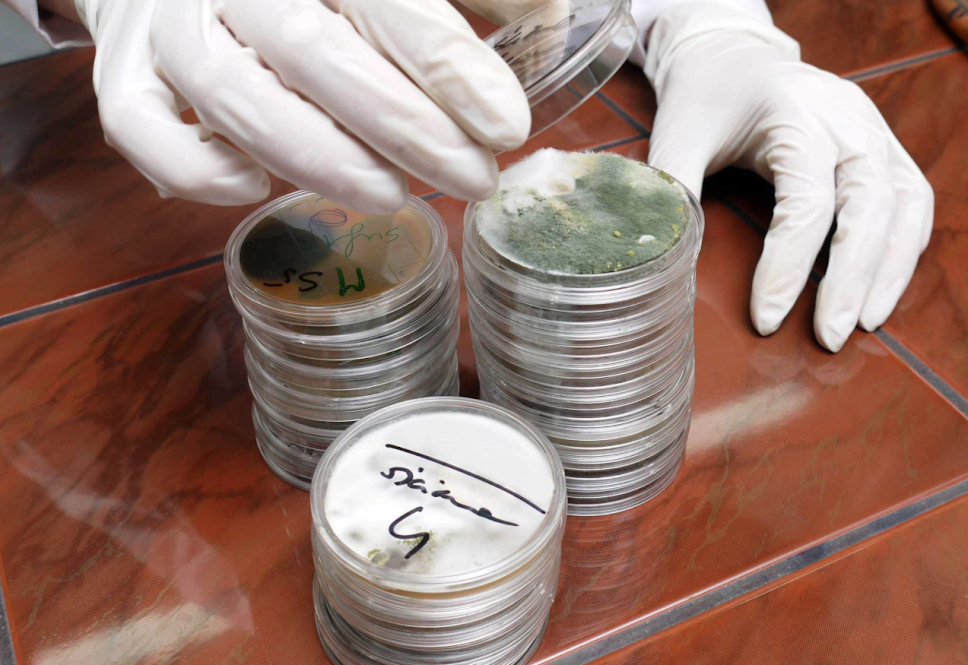

About Us
Chosen by 250+ clients for reliable mold inspection services


At Conroe’s Best Mold Testing & Inspection, we specialize in professional mold inspection and testing services for residential and commercial properties. Our goal is to provide clear, accurate information so our clients can make informed decisions about their property and health.
We use industry-standard testing methods and independent laboratory analysis to identify mold and moisture issues. We do not perform mold remediation, which means our inspections are honest, unbiased, and focused solely on accurate results.
Proudly serving Conroe and surrounding areas, we are committed to professionalism, transparency, and dependable service you can trust.
Watch How We Work

20
Years of Experience
Why Choose Us?
Focus On Getting Our Jobs Done Quickly
At Conroe’s Best Mold Testing & Inspection, we are committed to providing accurate, unbiased, and professional mold inspection services. Our focus is on helping homeowners and property owners understand potential mold issues clearly and confidently.
We use industry-standard inspection methods and lab-certified testing to ensure reliable results. Because we do not perform mold remediation, our assessments are completely independent—giving you honest information without pressure or upselling.
With a strong focus on professionalism, clear communication, and attention to detail, we guide you through the inspection process and explain findings in simple terms. From initial inspection to final report, our goal is to deliver dependable service, transparency, and peace of mind.
Address:
11610 Stidham Rd, Conroe, TX 77302
Email:
contact@moldtestingconroetx.com
Open Hours:
Mon-Sat: 9am – 6pm
J
